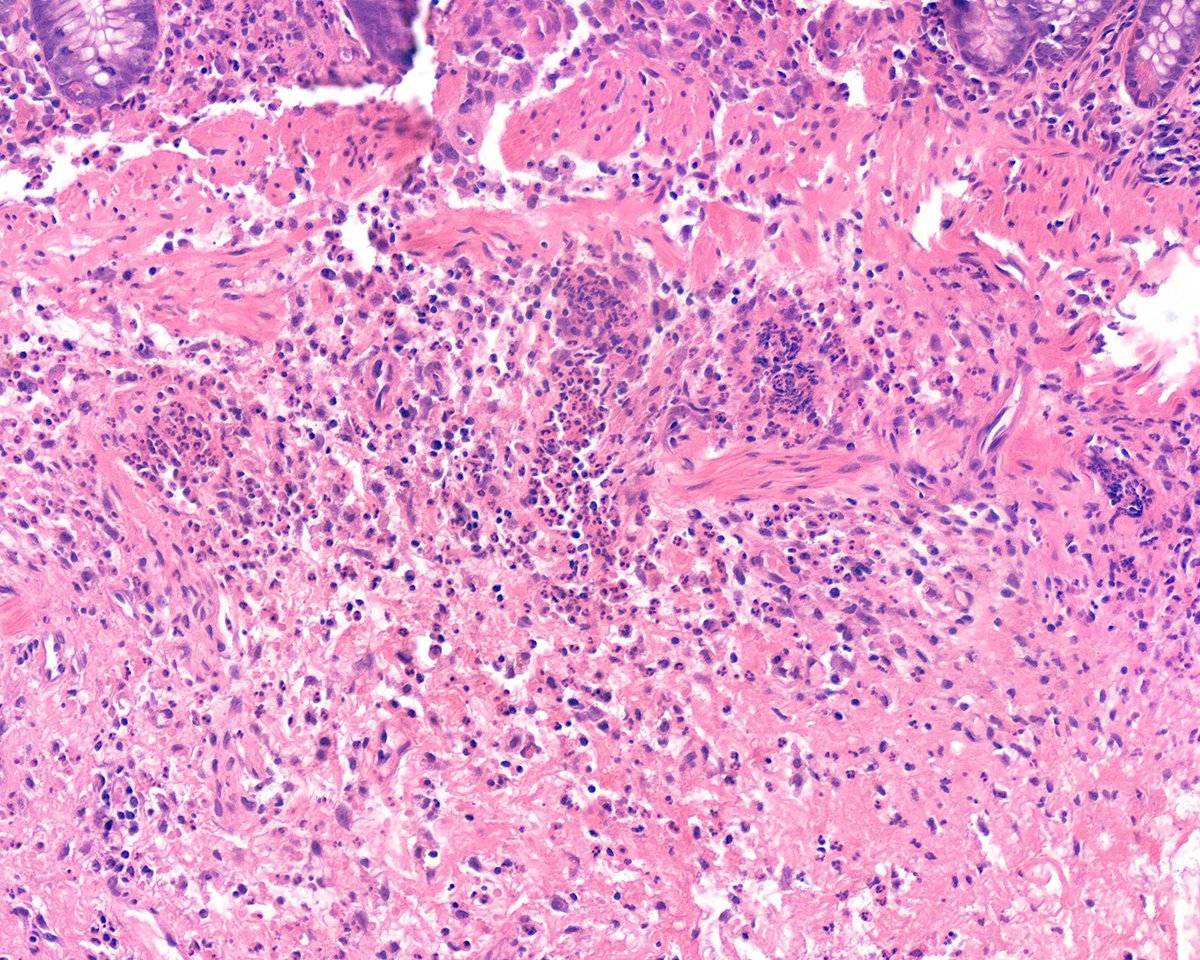
Surgical Pathology Cases tweet media
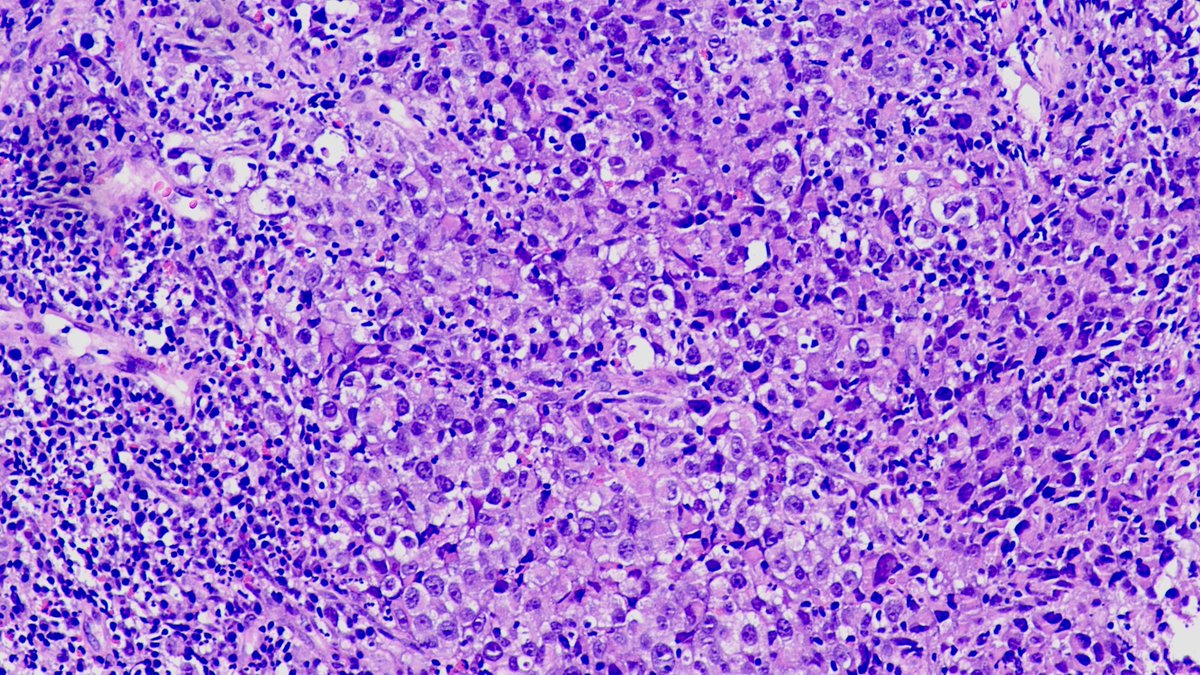
Sumanta Das tweet media
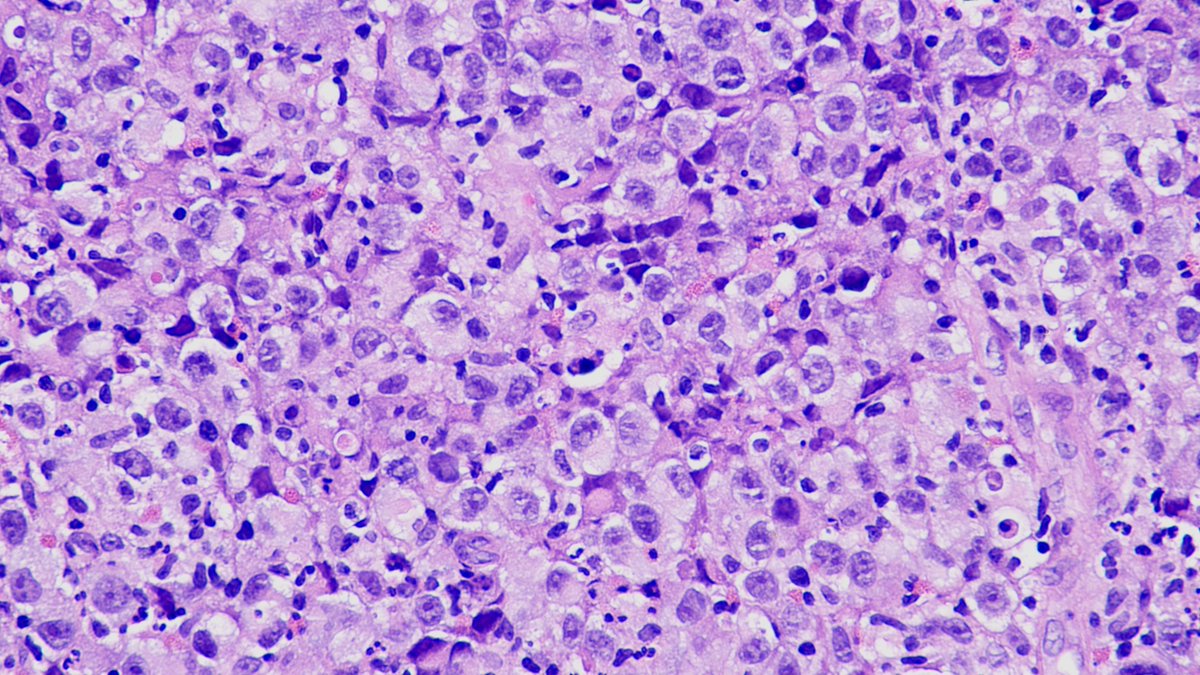
Sumanta Das tweet media
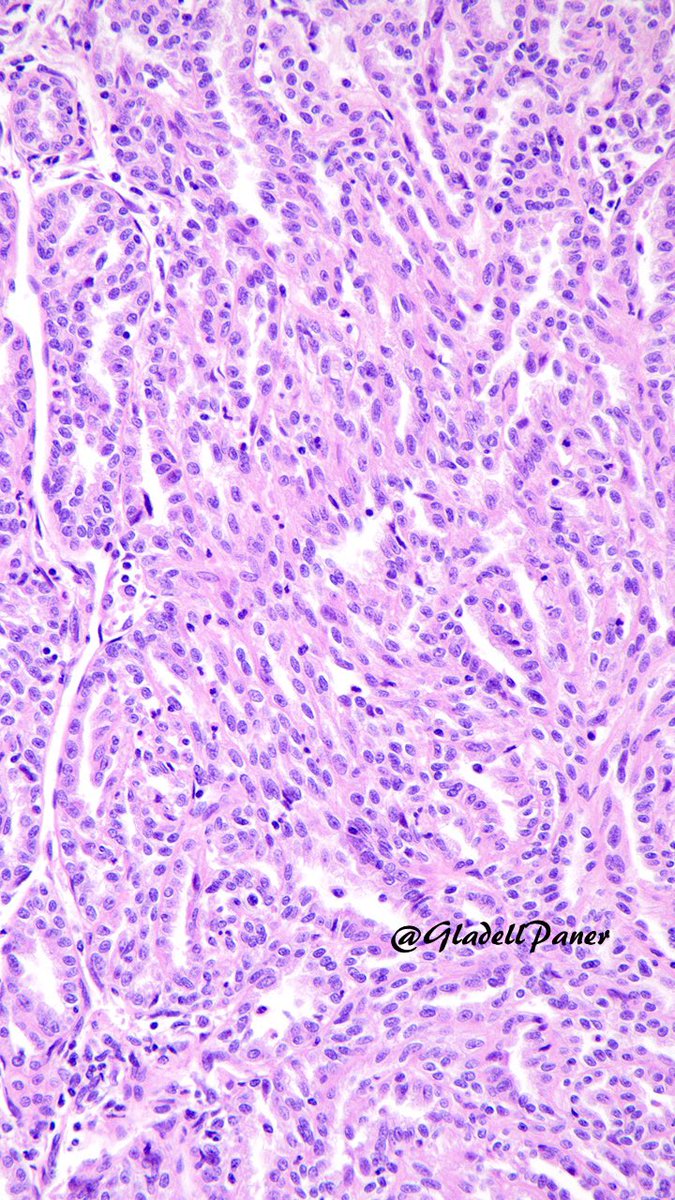
Gladell Paner, MD tweet media

Sabitlenmiş Tweet
iheartpath
3.8K posts

iheartpath retweetledi
iheartpath retweetledi

#GUpath classics:
bladder bx for hematuria
🔬urothelial carcinoma in situ (notice adjacent reactive urothelium on right side)




English
iheartpath retweetledi

🔬📸 "Blue Bridges" ~ Squamous Cell Intercellular Bridges in Skin Epidermis, AFB special stain ~ #Pathology #Histology #Dermpath #Dermatology #PathArt

English

“You and I are a team. Nothing is more important than our friendship” Mike Wazowski y James P. “Sulley” Sullivan. 📸 chorionic villi from @cjesteva

English

“If your heart is broken, make art with the pieces." Shane Koyczan #pathart Picture: breast, usual ductal hyperplasia.

English
iheartpath retweetledi


iheartpath retweetledi

Fruiting body Friday #frubofri
Why do so many fungi make fruiting bodies in cultures but so few do it in tissues (pathology)?
#pathbugs #crittersontwitter #pathology #pulmpath
Read details here:
journals.sagepub.com/doi/10.1177/10…

English
iheartpath retweetledi

I almost made a BIG MISDIAGNOSIS here!
80 F leg skin mass.
Dot-like + panCK & chromogranin.
Neg: CK20 synapto TTF-1 CD45.
WSI:kikoxp.com/posts/21603
More IHC 🤯kikoxp.com/posts/21605
Answer:youtube.com/watch?v=coeItf…
#pathology #pathTwitter #dermpath #dermtwitter

YouTube

English
iheartpath retweetledi
iheartpath retweetledi

iheartpath retweetledi
iheartpath retweetledi
iheartpath retweetledi
iheartpath retweetledi
iheartpath retweetledi

iheartpath retweetledi